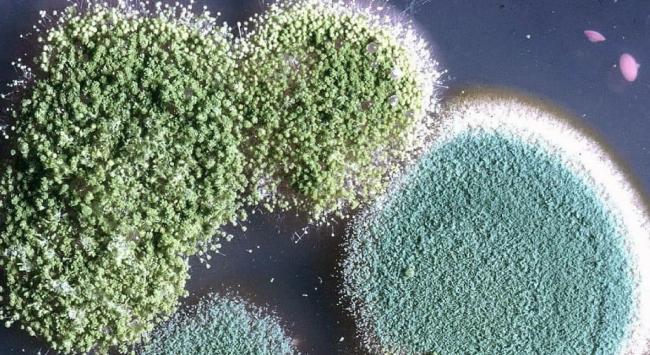

Вред от микроорганизмов: разное воздействие на человека
Токсическое действие может проявляться в виде легкой слабости, повышенной утомляемости, раздражительности. Как правило, люди думают, что это обычная усталость от работы. С течением времени у человека может появиться цирроз печени – одно из главных последствий.
Если человек регулярно употребляет вместе с едой плесень, то проживет он очень мало и болезненно. Среди последствий токсического воздействия можно отметить сердечно-сосудистые болезни, синусит, мигрень, кровотечения из носа, кашель.
Если говорить об аллергенном воздействии плесени, то она проявляется в виде аллергии кожи и слизистых. К примеру, аллергический ринит является достаточно распространенным заболеванием. А вот сенная лихорадка – один из самых распространенных ее видов, практически всегда обуславливается спорами грибков. Бронхиальную астму тоже провоцирует черная плесень.
Довольно часто аллергия на плесень наблюдается у детей. Поскольку восприимчивость к грибку у всех разная, тяжесть последствия от нахождения в зараженном месте тоже отличается.
Что по поводу канцерогенного воздействия, то оно проявляется в тот момент, когда грибок попадает в еду. Помните, если плесень все-таки образовалась, нет смысла срезать пораженный кусочек хлеба – от всего продукта необходимо сразу же избавиться.
Профилактика развития черной плесени
Подготовьтесь к зиме!
Об этом должен знать КАЖДЫЙ! НЕВЕРОЯТНО, НО ФАКТ! Ученые разработали уникальное средство, которое помогает восстановить иммунитет и подготовить его к различным атакам вирусов гриппа и даже восстановить его если вы уже болеете. Скоро осень, зима и весна – это то время, когда активность гриппа возрастает, а чтобы защитить себя и всю семью ученые советуют пить…
Чтобы защитить свой дом от развития в нем грибка и предупредить появление серьезных заболеваний, необходимо знать несколько простых правил.
Помещение нужно проветривать ежедневно как минимум дважды в сутки. Проветривания должны быть короткими, но интенсивными, то есть окна и двери желательно открывать на максимум. Необходимо обеспечить попадание свежего воздуха в наиболее благоприятные для грибка места – ванную комнату, кухню, чердак и подвал.
Нельзя длительное время находиться в плохо вентилируемых помещениях.
Нужна регулярная уборка в ванной комнате: мочалки необходимо просушивать, шторки для ванной постоянно расправлять и вытирать.
Следует внимательно следить за исправностью всей сантехники, ведь постоянные протекания также будут способствовать распространению грибка.
Белье нужно развешивать сразу же после стирки.
Используя пылесос, необходимо открывать окна и двери настежь. Проветривание поможет нивелировать .
При замене мусорного пакета нужно вымывать и высушивать ведро.
Необходимо применять кондиционер, чтобы создать нормальный микроклимат в помещении.
Черная плесень в доме вызывает множество заболеваний – от простого недомогания до онкопатологий. Поэтому при появлении черных, зеленых или синих пятен на потолке, стенах либо мебели, необходимо сразу бороться с этой проблемой. На сегодня существует много специальных средств, помогающих избавиться от грибка. А соблюдение профилактических мер предупредит его развитие.
Причины грибковой аллергии
Аллергия на грибок или плесень часто сопровождает другие аллергические реакции, в основном связанные с непереносимостью пыльцы растений или клещей домашней пыли.
Спровоцировать заболевание могут следующие факторы:
- наследственность по генетическому типу;
- длительное пребывание в сырых помещениях;
- непосредственный контакт с влажной землёй и перепревшей листвой, при огородных работах в весенний или осенний периоды;
- пониженный уровень иммунитета и защитных свойств организма;
- наличие других видов аллергии.
У взрослых послужить развитием болезни могут и другие причины, связанные с профессией или спецификой работы. В зоне риска находятся работники сельского хозяйства, лаборанты, работники пищевой промышленности и кормов для животных, шахтёры.
Научно-популярное видео:
Как обезопасить себя от плесени?
Ликвидировать негативное влияние плесени на организм человека можно лишь одним путем – полностью устранив все контакты с грибком. Причем сделать это надо качественно. Удаление пятен только с поверхности не даст результата, так как невидимые споры останутся и продолжат развиваться.
Если в доме уже есть плесень, надо избавиться от нее. Для этого используют народные или специальные средства. Еще один вариант – механически очистить все пораженные участки, а затем обработать их антисептическим препаратом.
Удаляя плесень и пользуясь химическими препаратами, нужно надеть маску и перчатки, чтобы защититься от вдыхания спор и ядовитых паров.
Важно не только устранить колонии грибка, но и предотвратить их повторное появление. Для этого нужно:
- поддерживать в доме нормальный уровень влажности;
- избегать перепадов температур;
- вовремя устранять протечки;
- часто проветривать;
- регулярно убираться;
- просушивать постельные принадлежности;
- оборудовать ванную и кухню системой вентиляции;
- в отопительный сезон поддерживать комфортную температуру, чтобы помещения не отсыревали из-за холода.
Кроме того, надо регулярно осматривать помещения на наличие плесени и, заметив первые признаки, грибка сразу же принимать меры.
Как проявляется негативная реакция?
Городские жители преимущественную часть суток проводят в закрытых помещениях, в воздухе которых находится большое количество микроорганизмов. Клетки плесневых грибов, проходя через дыхательные пути человека, имеют способность глубоко проникать в лёгочные ткани, вызывая в них патологические изменения.
Некоторые разновидности грибков вызывают у детей диатез, дерматит, астму.
Реакция на плесневые образования проявляется общими нарушениями работы систем жизнедеятельности организма.
Попадание спор в дыхательные пути можно определить по таким признакам:
- насморк с обильным выделением жидкости;
- кашель, который не проходит длительное время;
- ощущение покалывания в носу;
- частое чиханье;
- слезоточивость;
- хрипы, одышка;
- отёчность и заложенность в области носоглотки;
- удушье.
При попадании патогенных микроорганизмов в организм с пищей появляются такие симптомы:
- боль в животе;
- высыпания на коже;
- тошнота, рвота;
- жжение в гортани и ротовой полости.
В этом случае необходимо детально провести анамнез больного, чтобы отличить пищевое отравление от грибковой аллергии, поскольку методы лечения этих заболеваний различные.
После непосредственного контакта кожи человека с плесневыми образованиями наблюдаются:
- гиперемия участков кожных покровов;
- сыпь;
- зуд;
- отёчность поражённых мест.
Плесень может быть причиной для развития таких заболеваний:
- аллергический ринит – воспалительный процесс слизистой оболочки носа;
- мигрень – длительные и мучительные приступы головной боли;
- отит – воспаление тканей уха;
- бронхит;
- бронхиальная астма;
- заболевания сердечно-сосудистой системы;
- острое или хроническое отравление плесневыми грибами.
Все недуги, вызванные грибами, имеют хронический, затяжной характер и тяжело поддаются лечению.
При попадании спор в желудок и кишечник, возникает пищевая аллергия. Наиболее токсичными считаются грибы жёлтого цвета, которые поражают молоко, рыбу, субпродукты.
Обнаружив небольшой налёт в банке с консервированными фруктами, многие люди не придают этому особого внимания, не подозревая, что употребление продуктов с плесневыми бактериями и накапливание их в организме, может привести к онкологическому поражению печени.
Для приготовления элитных сортов сыра с плесенью или вина используют специально подготовленный материал, который не имеет ничего общего с налётом, поражающим продукты питания.
С помощью медицинских исследований выявлено более 100 токсических соединений, находящихся в плесени, высокая концентрация которых способна вызвать активный рост раковых клеток.
Тепловая обработка заплесневелых продуктов не действует на токсины, они являются опасными для здоровья человека. В любом случае поражённые продукты – хлеб, фрукты, крупы, овощи рекомендуется выбрасывать.
Меры профилактики
Чтобы не искать способы борьбы с чёрной плесенью, не стоит допускать её появления.
Для этого следует:
Регулярно проветривать квартиру, уделяя особое внимание ванной комнате и туалету.
Своевременно проводить уборку и дезинфекцию помещений.
Контролировать уровень влажности в жилых комнатах, подвальных помещениях и на общих площадках.
Не допускать появления конденсата.
Позаботиться о гидроизоляции подвала.
Проводить обработку антигрибковыми средствами для профилактики.
Позаботиться о достаточном уровне утепления стен, если они промерзают в зимнее время.


Как бороться с грибком в квартире?
Чтобы ликвидировать плесневые образования внутри помещения, используют специальные средства, обладающие противогрибковым действием, которые помогут избавиться от неё навсегда
Использовать химическое средство нужно с осторожностью, поскольку оно очень ядовито и токсично
Антисептическая грунтовка наносится на очищенную поверхность стен в квартире, удалят плесень и создаёт защиту для её появления в дальнейшем. К таким средствам относятся Фонгифлюид Альпа, Олимп стоп-плесень, Биотол-спрей, Мавикс-био.
Тем, кто не желает применять в жилых помещениях агрессивные химические вещества, можно использовать простые средства, находящиеся в каждом доме. Уничтожить плесень поможет хозяйственное мыло, уксус, сода, жидкий отбеливатель для вещей, содержащий хлор, эффективно удаляет грибок масло чайного дерева.
При проведении уборки помещения необходимо соблюдать правила:
- использовать специальную одежду и средства индивидуальной защиты – халат, респиратор;
- перед обработкой налёт обильно увлажнить, чтобы ограничить распространение спор;
- обнаруженный участок, поражённый плесенью, обработать противогрибковым раствором 3 раза, каждый раз до полного высыхания;
- очищать место от плесени рекомендуется с помощью жёсткой щётки, до чистой поверхности;
- проветрить квартиру, обеспечив доступ свежего воздуха;
- провести влажную уборку.
Как избавиться от грибка в квартире? Видео:
Чистоту в жилом помещении необходимо поддерживать постоянно, не забывая просматривать места, в которых может образовываться плесень.
Присутствие плесени в жилом помещении – явление, опасное для здоровья человека. Кроме аллергических реакций, она может вызывать развитие более серьёзных заболеваний. Обнаружив плесень в квартире, необходимо срочно принимать меры по её удалению и очищению окружающего пространства.
Группы микроорганизмов
- К первой группе относятся плесневелые грибки. Они поражают строительные материалы (бетон, камень) и поверхности, обработанные краской, штукатуркой, обоями. Имеют различные цветовые оттенки, включая черный цвет. Их хорошо видно на зараженных местах, в том числе на стенах жилья. Сначала они располагаются точечно, а потом образовывают пятна из точек, постепенно увеличиваясь в размерах. Некоторые грибки из этой группы способны светиться в темноте.
- Вторая группа состоит из грибков синего цвета. Они губительно воздействуют на древесные породы, особенно сосну. Владельцы деревянных построек должны внимательно относиться к данному виду плесени, оберегая постройки профилактическими обработками.
- Третью группу представляют гнилостные грибки. Это микроорганизм бурого цвета, разрушающий всю древесину, без исключения. Гнилостные изменения проявляются черными (или иного цвета) полосами на деревянных поверхностях.
Относится к первой группе микроорганизмов и пагубно влияет на человеческий организм. Особенно опасна она для старшей и младшей возрастных категорий, лиц со слабой иммунной системой и будущих мам.
Лечение
При единичном отравлении плесенью достаточно проведения мер первой помощи, призванных вывести из организма человека токсичные вещества, хроническое же заражение требует комплексного медикаментозного лечения. Если анализы точно диагностировали эту болезнь, то лечащий врач назначает:
- противогрибковые препараты, подбираемые на основании анализов;
- лекарства, оказывающие терапевтическую поддержку функционированию почек и печени (эти органы особенно уязвимы в процессе интенсивного выведения токсинов);
- пробиотики, необходимые для того, чтобы в кишечнике восстановилась и поддерживалась полезная микрофлора.
Лечение людей, у которых заражение плесенью произошло через органы дыхания, усложняется тем, что вызывает вторичные заболевания (трахеит, астму, бронхит, пневмонию, гайморит и так далее). Здесь требуется проходить длительную терапию, выполняя предписания специалиста.
Чем грозит черная плесень в доме
Чаще всего при малых концентрациях плесневых грибов невозможно сразу ощутить то ущерб, который они оказывают. Однако при продолжительном воздействии плесень может стать причиной серьезных заболеваний.
Влияние плесени на организм человека приводит к развитию у него токсической интоксикации. Последняя вызвана тем, что грибок проникая в пищеварительную систему, вызывает у человека неприятные симптомы в желудочно-кишечном тракте и абдоминальные боли. В случае попадания плесневых грибков на слизистые оболочки у человека развивается аллергическая реакция. Причиной развития аллергии могут стать как активные, так и уже мертвые грибки. Кроме того при нахождении плесени в доме человек может быть подвержен и прямому инфицированию вредными веществами. В группу риска входят люди с уже ослабленным другой болезнью иммунитетом.
Продолжительное существование плесневых пятен в жилом помещении также становится виновником развития тяжелых патологических отклонений. В их число входят заболевания кожи, вызванные осевшими на кожный покров плесневыми спорами. Развиваются заболевания суставно-ревматического комплекса, для которых характерно ухудшение общего состояния человека, слабость, сонливость, а также развитие головных болей. Кроме того раздражение слизистых оболочек может вызвать появление хронического насморка, сухого кашля и воспаления глазной слизистой. Токсины плесени ведут к развитию болезней, поражающих дыхательные пути, а также при долговременном контакте с организмом провоцируют активность раковых клеток, ведущих к появлению злокачественных образований.
Как обезопасить себя от черной плесени
Тестирование на наличие плесени
Проверенный и эффективный метод проверки наличия плесени – удаление наиболее неблагоприятных условий окружающей среды как минимум на одну неделю. Если это ваш дом, уберите из него как можно больше вещей.HERTSMI-2
Это тест, который выявляет самые опасные виды плесени: Aspergillus penicilloides, Aspergillus versicolor, Chaetomium globosum, Stachybotrys chartarum и Wallemia sebi.
ERMI Индекс относительного уровня окружающей среды (ERMI) был разработан агентством по охране окружающей среды США (EPA) для оценки общей нагрузки на заданное пространство путем количественной оценки наличия 36 форм и сравнения их со справочной базой данных.
Воздушные тесты
Эти тесты позволяют обнаружить в воздухе споры различных видов плесени. Обычно их выполняют специалисты по качеству воздуха в помещениях. Недостатки: в этих тестах не учитываются фрагменты плесени и другой генетический материал. Также им часто не удается обнаружить вид Stachybotrys, выделяющий тяжелые споры, которые быстро оседают на пол. К тому же они дорогие.
Персональные тесты
Обычно достаточно пробы мочи для проверки наличия плесени или микотоксинов в организме. Иногда также проводится анализ слизи из носа и мокроты. Биопсия ткани требуется редко. Рекомендуются тесты на:
VIP Вазоактивный кишечный полипептид (VIP) – это гормон с рецепторами в гипоталамусе, области мозга, которая регулирует вегетативную нервную систему и гипофиз. Больные имеют низкий уровень данного гормона.
MSH Меланотропин альфа (альфа-меланотропный гормон, MSH) обладает многочисленными противовоспалительными функциями и регулирует нейрогормональную активность. Большинство больных (95%) имеют низкий уровень гормона.
TGF BETA-1 Трансформирующий фактор роста бета-1 (TGF beta-1) – это белок, который регулирует иммунные пути, а также контролирует рост и деление клеток. Если его уровень слишком высок, это может вызвать аутоиммунную реакцию.
C4A – воспалительный маркер, который сигнализирует об иммунном ответе, вызванном контактом с плесенью.
Группы микроорганизмов
- К первой группе относятся плесневелые грибки. Они поражают строительные материалы (бетон, камень) и поверхности, обработанные краской, штукатуркой, обоями. Имеют различные цветовые оттенки, включая черный цвет. Их хорошо видно на зараженных местах, в том числе на стенах жилья. Сначала они располагаются точечно, а потом образовывают пятна из точек, постепенно увеличиваясь в размерах. Некоторые грибки из этой группы способны светиться в темноте.
- Вторая группа состоит из грибков синего цвета. Они губительно воздействуют на древесные породы, особенно сосну. Владельцы деревянных построек должны внимательно относиться к данному виду плесени, оберегая постройки профилактическими обработками.
- Третью группу представляют гнилостные грибки. Это микроорганизм бурого цвета, разрушающий всю древесину, без исключения. Гнилостные изменения проявляются черными (или иного цвета) полосами на деревянных поверхностях.
Относится к первой группе микроорганизмов и пагубно влияет на человеческий организм. Особенно опасна она для старшей и младшей возрастных категорий, лиц со слабой иммунной системой и будущих мам.
Какую опасность представляет черная плесень для человека?
Опасна ли плесень?
На основе современных знаний можно сказать, что она ответственна за следующие 3 группы негативных факторов: пищевые отравления, аллергии и собственно грибковые патологии в организме — микозы. Заплесневелые продукты питания способны вызывать такие же токсичные отравления, что и всем известные ядовитые грибы. Самыми опасными из них ученые называют афлатоксины, являющиеся производными гриба Aspergillus flavus, окрашенными в желто-зеленый цвет.
В благоприятной среде они могут расти на чем угодно (речь идет о съедобных продуктах) — бобах, орехах, кофейных зернах и какао, конфитюрах и сушеной рыбе. Но, оказывается, плесень не обязательно съесть, чтобы нанести вред организму. Более того, самым опасным среди остальных ее видов является тот, который мы не едим.
Науке сегодня известно от 2 до 4 сотен разновидностей микотоксинов, но и у тех далеко не у всех до конца изучена степень токсичности. Микологи полагают, что нулевого уровня опасности среди них не существует и даже те из них, что имеют ничтожно малый негативный фактор, обладают накопительной способностью в человеческом организме. Однако существует важная оговорка: выработка токсинов происходит далеко не всегда, для этого необходимо создание определенных условий.
Вредоносное воздействие
Все организмы на планете имеют свое предназначение и, несмотря на важность присутствия черных форм плесени в экосистеме, ее наличие в жизни человека приводит к медицинским проблемам. Токсины, выделяемые микроорганизмами, отравляют дыхательные пути и органы
Черная плесень питается омертвевшими органическими веществами и размножается с помощью спор стремительно. Темпы ее роста невозможно контролировать.
Влияние на здоровье при воздушном контакте и прямом одинаково опасно. Если не бросить все силы на ее уничтожение, то последствиями грибковых поражений стен для жильцов могут быть:
- аллергия;
- астма;
- дерматит;
- ринит;
- бронхит.
- конъюнктивит.
Черные грибки способны спровоцировать туберкулез, удушье и множество других проблем. Чтобы оградить себя от их воздействия, надо изначально не пренебрегать профилактикой, не давая микроорганизмам не единого шанса на поселение в доме.
Виды грибков
Как уберечься от «нападения» грибка?
Прежде всего необходимо установить причину появления «головной боли» в конкретных местах и продумать меры по устранению повышенной влажности. При этом нужно знать, что отопление и вентиляция должны функционировать на уровне норм проектирования, стены помещений должны иметь теплосопротивление строго в соответствии с проектом, а отопительные приборы грамотно размещены в торцевых комнатах. Обнаруженные маленькие пятна обработать перекисью водорода или столовым уксусом – в качестве первой неотложной меры.
Устанавливать только «распашные» пластиковые окна и проветривать помещения, открывая окна полностью, стараться устанавливать в помещениях вентилируемые фасады .
Не закрывать плотно двери ванных комнат, оставляя возможность для выравнивания температуры и влажности.
Провести обработку зараженных поверхностей специальным средством, если необходимо, то до уровня бетонной (кирпичной) поверхности.
Народные средства, помогающие в борьбе с плесневым грибком:
Поверхность обрабатывается креозотом;
Раствором, содержащим в 10 л воды 1-1,5 кг фторида натрия, либо 1 кг медного купороса, либо 1,5 кг железного купороса. Можно в раствор вводить одновременно и железный, и медный купорос (по 0,5 кг);
Раствором, содержащим в 10 л воды 0,5 кг медного купороса и 1,5-2 л уксусной кислоты;
Раствором, содержащим в 10 л воды 0,9 кг буры, 0,4 кг борной кислоты и 1,4 л столового уксуса.
Приготовленный раствор нагревают до 50-70°С и распыляют или наносят кистью на те участки, которые поражены грибком. Древесине дают высохнуть, а через месяц обработку повторяют; антраценовое масло глубоко проникает в поры дерева и начисто уничтожает грибок, однако после такой обработки дерево хорошо окрашивается лишь через несколько лет. Другие пораженные строительные материалы рекомендуется обработать медным купоросом, канцелярским клеем или мочевиной. Однако народные средства лишь на время останавливают рост плесени.
Чтобы узнать больше, читай
В результате воздействия постоянной влаги и теплоты на стенах и потолке может появиться грибок. Безусловно, черная плесень вред для здоровья приносит, просто не каждый задумывается об этом.
Обустраивая интерьер квартиры или частного дома, жильцы стараются придать ему оригинальности, но забывают о серьезных проблемах. Так, черная плесень не только портит вид помещения, но и негативно сказывается на самочувствии домочадцев. Почему плесень несет опасность для человека, и какие патологии вызывает, расскажем далее.
Как избавиться от черной плесени?
Тщательное удаление плесени может облегчить симптомы. Это может потребовать тщательного удаления плесени со всех поверхностей в доме или на рабочем месте человека и принятия мер для их предотвращения. Существует много чистящих средств, которые могут уничтожить плесень и предотвратить ее возвращение. Кроме того, можно приготовить моющий раствор в домашних условиях, добавив 1 стакан бытового отбеливателя на 3,5 литра воды
При работе с отбеливателем или агрессивными чистящими средствами крайне важно использовать защитные перчатки и очки. Необходимо полностью очистить всю комнату и убедиться, что устранены все признаки плесени
Также надо высушить поверхности, чтобы избежать загрязнения в будущем. Рекомендуется по возможности очистить все фильтры, вентиляционные отверстия, чтобы предотвратить рост плесени в системах кондиционирования воздуха и увлажнителях.
Пористые предметы с плесенью, такие как матрацы, ковры или гипсокартон, очистить сложно. Их необходимо заменить или нанять профессионального уборщика
Во время уборки важно максимально вентилировать помещение, открывая двери и окна или включая вентиляторы
Профилактические меры
Для эффективного предотвращения случаев отравления плесенью достаточно придерживаться стандартных норм гигиены:
- избегать длительного нахождения в комнатах, где на стенах или в системе вентиляции развивается грибок;
- при невозможности выполнения предыдущего пункта необходимо регулярно проветривать воздух в помещениях, пораженных плесенью;
- при хранении овощей и картофеля в подвальных помещениях стены и пол должны регулярно обрабатываться противогрибковыми составами;
- пищевые продукты дома должны храниться в надлежащих условиях (в холодильнике при правильной температуре, в регулярно очищаемой хлебнице и прочее);
- нельзя принимать в пищу продукты, на поверхности которых появилось хотя бы немного плесени (даже незначительное ее количество может вызвать в организме сильную выработку микотоксинов, способных привести к острому отравлению).
Помощь после отравления должна оказываться максимально быстро для предотвращения перетекания его в острую или хроническую стадию.
